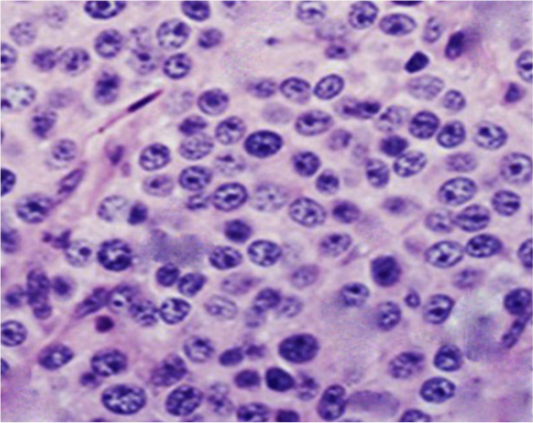

Advances in Animal and Veterinary Sciences
Images showed the distribution of the internal pudendal and penial arteries inside the penial tissue
A- Origin of penial artery. B- branches of penial artery at penial root, C- branches of dorsal penial artery in penial body, D- dorsal penial artery at glans penis.
1- bulb of the penis, 2- bulbospongiosus muscle, 3- bulbus glandis, 4- prepuce, 5- ischiocavernosum muscle , 6- internal pudendal artery, 7- caudal rectal artery, 8- penial artery of the penis, 9-uretheral artery, 10- the artery of the bulb of the penis, 11- deep artery of penis, 12- dorsal artery of penis, a- preputial br., b- superficial br., c- deep br., 13- dorsal artery of penis, 14- fibrocartilaginous tip of Os-penis.
TVT and its response to vincristine therapy in male dogs. (A and B) showed an irregular, large, friable, reddish TVT mass (multinodular, cauliflower-like mass) overgrowth on the glans penis. (C) One-week post-treatment with the vincristine sulfate, the lesion presented an appreciable reduction. (D) By the end of the second week of vincristine therapy, the tumor mass had completely regressed.
Photomicrograph showing histopathological analysis of biopsies from infected TVT dogs (Gp II). The neoplastic cells were numerous, round to oval, of relatively uniform size with indistinct outlines growing in a scanty fibrous stroma. The cells had lightly eosinophilic granular cytoplasm and large, round to ovoid nuclei with prominent nucleoli. Mitotic figures were also plentiful (H&E, X400).
Ultrasonograms showing internal pudendal artery (I Pu.A.) (A), dorsal penile artery (Do Pe.A) (B), and deep penile artery (De Pe.A) (C), diameters (mm) in dogs suffered from TVT.
Mean ±SD internal pudendal artery (I Pu.A) (A), dorsal penile artery (Do Pe.A) (B), and deep penile artery (De Pe.A) (C) cross-sectional diameters (mm) during the first and second week before and after treatment by vincristine compared to control group.
Mean ± SD internal pudendal artery (I Pu.A.) (A), dorsal penile artery (Do Pe.A) (B), and deep penile artery (De Pe.A) (C) resistance index (RI) and pulsatility index (PI) during the first and second week before and after treatment by vincristine compared to control group.
Mean ± SD internal pudendal artery (I Pu.A), dorsal penile artery (Do Pe.A), and deep penile artery (De Pe.A) blood flow rate (bpm) during the first and second week before and after treatment by vincristine compared to control group.